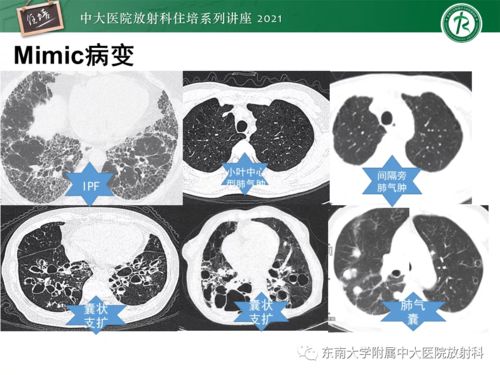
艾滋病病毒在昆虫体内 艾滋病病毒在昆虫体内

艾滋病病毒在昆虫体内
性病 2025-11-19 10:26女性性病www.xingbingw.cn
生物学机制揭示HIV与蚊子的不解之缘
HIV,这个专门盯上人类免疫细胞的逆转录病毒,它的生存与复制都离不开人类CD4+ T细胞提供的特定环境。而对于昆虫来说,体内缺乏这样的宿主细胞。当蚊子饱吸人血后,HIV病毒进入其中肠,但这里的消化酶可不是它的对手,病毒会被迅速分解。更无法迁移到唾液腺,因此无法继续其传播旅程。
传播条件受限:蚊子无法传递HIV的奥秘
蚊子的喙部残留的血液量极其微小,仅约0.00004毫升。这对于HIV病毒来说,简直是杯水车薪。即便病毒想趁机传播,也无法突破这一微量的限制。而且,病毒在昆虫体内的生存时间极其短暂,仅数分钟至数小时,根本无法完成复制或传播所需的生命周期。
全球监测数据的印证
世界卫生组织经过全球范围内的监测与研究,明确指出:至今尚未发现通过蚊虫叮咬传播艾滋病的病例。相比之下,疟疾等病原体能够在蚊子的体内完成复杂的生命周期,但HIV却不具备这样的“待遇”。
正确传播途径与公众防护建议
虽然蚊虫叮咬不会传播HIV,但我们仍不能掉以轻心。HIV主要通过性接触、血液或体液的交换以及母婴传播。防蚊措施仍然必要,主要是为了预防其他虫媒疾病,如疟疾、登革热等。在享受夏日的也别忘了保护自己,远离蚊虫的侵扰。
上一篇:自己有艾滋病老婆有外遇
下一篇:没有了